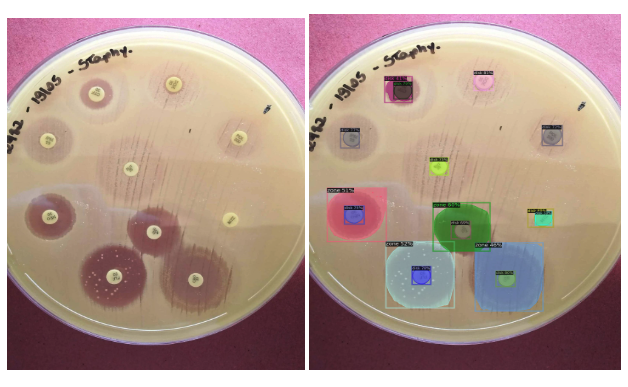
Antibiogram Zone Detector

Hi, I'm Divyansh
A data enthusiast pursuing a Master's in Applied Data Science at the University of Florida. I love building ML and AI driven solutions that make a real impact.
class Divyansh:
def passion(self):
return "AI + Data"